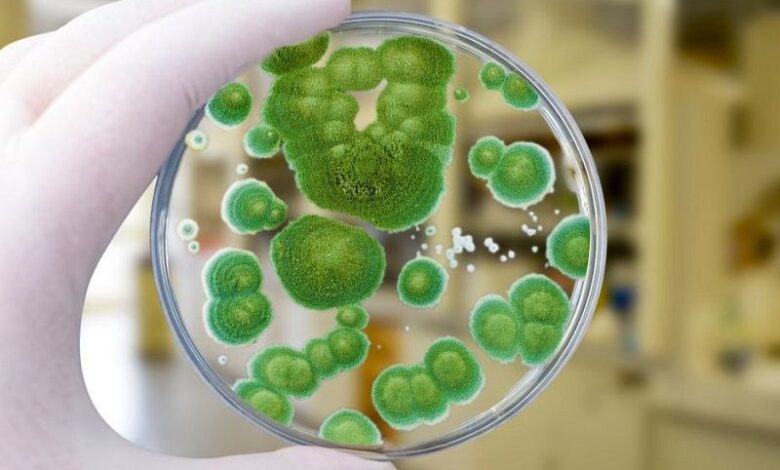
плесень грибок

Эволюция грибков и угрозы для человека
Глобальное потепление и масштабные изменения окружающей среды открывают новую, тревожную главу в отношениях человека и природы. Среди неожиданных последствий — стремительный рост грибковых инфекций, угрожающих сельскому хозяйству, экосистемам и, что особенно важно, здоровью людей. В этом контексте новаторская работа ученых из Кильского университета и Института эволюционной биологии Макса Планка в Плене (MPI-EvolBio) проливает свет на удивительный и потенциально опасный эволюционный механизм.
Исследование, опубликованное в журнале Nature Communications, показывает, что путь от безвредного обитателя почвы до патогена человека может быть короче, чем думали, и лежит не через приобретение смертоносных генов, а через тонкую оптимизацию собственного клеточного производства.
Исследовательская группа под руководством профессоры Евы Штукенброк сфокусировалась на сравнительном анализе геномов грибков из рода Trichosporonales, который объединяет как безопасные виды, так и патогены, опасные для людей с ослабленным иммунитетом. Первоначальная гипотеза ученых предполагала, что патогенные свойства обеспечены специальными «генами вирулентности». Однако реальность оказалась сложнее и интереснее. Генетический состав безвредных и опасных видов оказался поразительно сходным. Ключевое различие крылось не в наличии определенных генов, а в эффективности их использования.
Оказалось, что патогенные для человека грибки разработали стратегию сверхэффективного производства белков, задействованных в метаболизме жиров (липидов). Этот адаптационный механизм основан на оптимизации процесса трансляции — финальной стадии реализации генетической информации, когда на матрице мРНК собирается белковая молекула.
У патогенных грибов молекулы транспортной РНК (тРНК) идеально соответствуют определенным кодонам (сигналам) в мРНК, кодирующим белки липидного обмена. Это «технологическое усовершенствование» позволяет клетке производить нужные ферменты быстрее и в большем количестве. Поскольку организм млекопитающих, в отличие от почвы, представляет собой среду, богатую липидами, такая способность дает решающее преимущество для колонизации и выживания в новых условиях.
Лабораторные эксперименты подтвердили эту теорию. Грибки с оптимизированными генами жирового обмена демонстрировали значительно лучший рост в средах, насыщенных липидами, что служит прямой иллюстрацией их готовности к адаптации в организме хозяина. Таким образом, эволюционный шаг к патогенности может заключаться не в кардинальной перестройке генома, а в относительно быстрой «перенастройке» существующего аппарата синтеза белка под новые диетические условия — переход с «углеводной диеты» почвы на «жирную диету» организма млекопитающих.
Это открытие имеет далеко идущие последствия для общественного здравоохранения. Оно предполагает, что потенциальных угроз может быть значительно больше, поскольку многие современные безвредные грибки, особенно те, что уже способны выдерживать температуру тела человека, несут в себе скрытый потенциал патогенности. В условиях глобального потепления, роста числа пациентов с иммунодефицитами и повсеместной устойчивости к противогрибковым препаратам такой эволюционный путь становится все более вероятным.
Исследователи подчеркивают необходимость превентивного геномного мониторинга: выявляя виды с признаками подобной метаболической оптимизации, можно попытаться предсказать и подготовиться к появлению новых патогенов до того, как они станут серьезной проблемой. Эта работа меняет парадигму понимания грибковой патогенности, показывая, что угроза может развиться быстро и почти незаметно, прячась не в новых генах, а в совершенстве владения старыми.